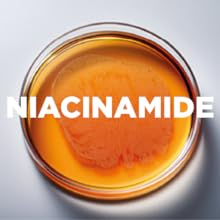
Small manufacture image 4

Customer Services
Copyright © 2025 Desertcart Holdings Limited
Desert Online General Trading LLC
Dubai, United Arab Emirates










💧 Elevate your glow game — hydration that works as hard as you do!
Skin Republic's Hyaluronic Acid 1% with Niacinamide Face Serum is a dermatologist-tested, clinically proven hydrating serum that boosts skin moisture by 22% for over 5 hours. Formulated with smart hyaluronic acid and pore-minimizing niacinamide, it improves texture, brightens skin, and is suitable for all skin types, making it the perfect daily essential for professionals seeking a polished, radiant complexion.

| Manufacturer | Skin Republic |
| Item model number | SR061 |
| Product Dimensions | 12.1 x 38 x 38 cm; 32 g |
| ASIN | B08YZ43XQC |
Trustpilot
4 days ago
1 month ago